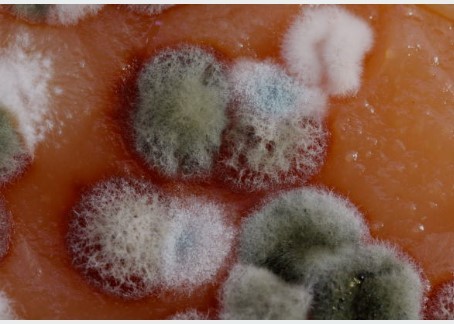

Mysophobia, also known as germophobia or germaphobia, is the fear of dirt, germs, or contamination. This specific phobia can significantly impact a person’s daily life and cause a variety of distressing symptoms and behaviors. Here’s an explanation of mysophobia, including its causes, symptoms, and potential treatment options:
Causes:
The exact cause of mysophobia is not always clear, but several factors may contribute to its development:
- Traumatic Experience: Some individuals with mysophobia may have had a traumatic experience related to illness or contamination in the past, leading to an exaggerated fear of germs.
- Learned Behavior: People may develop mysophobia if they witness family members or caregivers displaying excessive cleanliness and germ-avoidance behaviors, leading them to model these behaviors.
- Media Influence: Media coverage of infectious diseases, pandemics, or cleanliness-related stories can exacerbate mysophobia or trigger its development.
- Personality Traits: Individuals with certain personality traits, such as high levels of anxiety or perfectionism, may be more prone to developing mysophobia.
Symptoms:
Mysophobia can manifest in various ways, and the severity of symptoms can vary from person to person. Common symptoms include:
- Excessive Hand Washing: A person with mysophobia may wash their hands frequently and obsessively, often to the point of causing skin irritation or damage.
- Avoidance Behaviors: Individuals may go to great lengths to avoid situations or places they perceive as dirty or contaminated, leading to social isolation or disruptions in daily life.
- Fear of Touch: A strong fear of physical contact with others or surfaces can be a hallmark of mysophobia.
- Anxiety and Panic Attacks: Exposure to perceived sources of contamination can trigger intense anxiety or panic attacks.
- Preoccupation with Cleanliness: Constant thoughts about cleanliness, germs, or contamination can dominate a person’s thinking.
- Compulsive Cleaning: Excessive cleaning and disinfecting of personal belongings, living spaces, and surroundings is common.
Treatment:
Mysophobia, like other specific phobias, is treatable. Effective treatment options include:
- Cognitive-Behavioral Therapy (CBT): CBT is often the primary treatment for mysophobia. It helps individuals identify and challenge irrational thoughts and beliefs related to cleanliness and contamination.
- Exposure Therapy: Gradual exposure to feared situations or objects can help desensitize individuals to their fears. This technique is often used in combination with CBT.
- Medications: In some cases, medication, such as selective serotonin reuptake inhibitors (SSRIs) or anti-anxiety medications, may be prescribed to manage the symptoms of anxiety and obsessive-compulsive tendencies associated with mysophobia.
- Group Therapy: Group therapy sessions can provide support and a sense of community for individuals with mysophobia. Sharing experiences and coping strategies can be beneficial.
- Self-Help Techniques: Learning relaxation techniques, mindfulness, and stress-reduction strategies can help individuals manage anxiety related to mysophobia.
- Support System: Family and friends can play a vital role in supporting someone with mysophobia. Understanding and empathy can go a long way in helping the individual manage their fear.
It’s essential to seek help from a mental health professional if mysophobia significantly interferes with daily life or causes distress. With the right treatment and support, individuals with mysophobia can learn to manage their fear and improve their quality of life.










